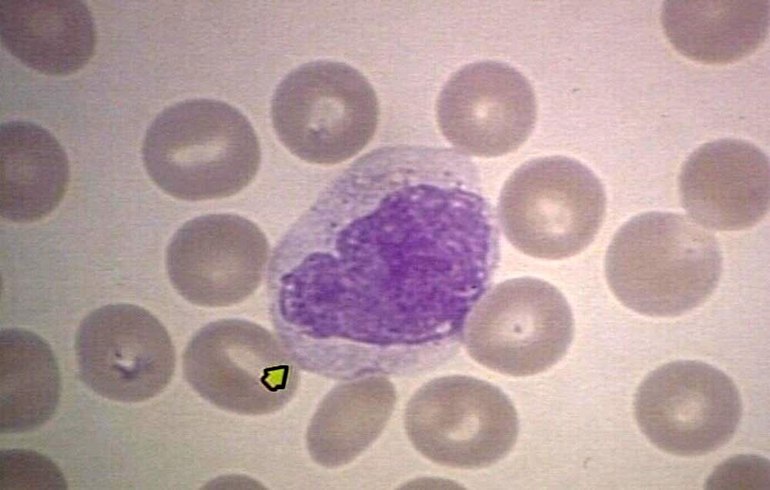
Недостаток моноцитов

Пониженный уровень лейкоцитов в крови, или лейкопения, может указывать на различные заболевания и состояния, требующие внимания. Белые кровяные клетки важны для иммунной системы, защищая организм от инфекций. В статье рассмотрим причины снижения уровня лейкоцитов, симптомы, диагностику и методы лечения лейкопении. Эта информация поможет тем, кто столкнулся с этой проблемой, и подскажет, какие шаги предпринять для восстановления здоровья.
Причины лейкопении
Лейкопению можно обнаружить с помощью общего и расширенного анализа крови. В лабораторных условиях после обработки клеток определяют соотношение гранулоцитов и агранулоцитов. Клеточные популяции делятся на несколько категорий: нейтрофилы, эозинофилы, базофилы, моноциты и лимфоциты.
Если снижение нормальных показателей сохраняется на протяжении длительного времени, это может представлять опасность из-за недостатка иммунных клеток. При лейкопении уровень лейкоцитов может опуститься до 1,5*10^9/л. Существует также врожденная форма этого заболевания, которая встречается в одном случае на 300 тысяч человек.
Существует несколько основных факторов, способствующих снижению уровня белых кровяных клеток:
- Физиологические причины.
- Недостаток необходимых элементов, участвующих в образовании лейкоцитов.
- Нарушения в работе костного мозга.
- Отравление тканей токсичными веществами.
- Прием медикаментов.
- Заболевания внутренних органов.
- Эндокринные расстройства (например, тиреотоксикоз, синдром Кушинга).
- Вирусные инфекции: корь, малярия, гепатит, септический эндокардит, брюшной тиф.
https://youtube.com/watch?v=1zFMpZ8SwSc
Пониженное количество лейкоцитов в крови, или лейкопения, вызывает у врачей серьезные опасения, так как это может указывать на различные заболевания или состояния. Специалисты рекомендуют в первую очередь обратиться к врачу для определения причины этого явления. Важно провести полное обследование, включая анализы и, при необходимости, дополнительные исследования. Врач может назначить лечение, направленное на устранение основной проблемы, будь то инфекция, аутоиммунное заболевание или влияние лекарств. Кроме того, врачи советуют обратить внимание на образ жизни: сбалансированное питание, достаточное количество витаминов и минералов, а также регулярные физические нагрузки могут способствовать улучшению состояния. В некоторых случаях может потребоваться консультация гематолога для более глубокого анализа ситуации.
Физиологические отклонения
Лейкопения, вызванная физиологическими факторами, наблюдается довольно редко. У всего лишь 10% людей, у которых не выявлены органические или функциональные нарушения в костном мозге, может быть диагностирована данная болезнь. При этом уровень лейкоцитов не опускается ниже 2*10^9/л.
Снижение уровня лейкоцитов может происходить:
- Ночью во время сна, когда активируется блуждающий нерв.
- В результате посещения саун, бань или принятия горячих ванн.
- Из-за стрессовых ситуаций.
При таких нарушениях форменные элементы крови могут перемещаться в другие участки сосудистой системы.
| Причина пониженных лейкоцитов (лейкопении) | Что делать (рекомендации) | Дополнительная информация |
|---|---|---|
| Инфекции (вирусные, бактериальные) | Обратиться к врачу для диагностики и лечения основной инфекции. | Врач может назначить противовирусные, антибактериальные препараты. Важно не заниматься самолечением. |
| Прием некоторых лекарств (химиотерапия, иммунодепрессанты, некоторые антибиотики) | Обсудить с врачом возможность корректировки дозы или замены препарата. | Не прекращайте прием лекарств самостоятельно. Врач оценит риски и пользу. |
| Аутоиммунные заболевания (СКВ, ревматоидный артрит) | Следовать рекомендациям ревматолога, принимать назначенные препараты. | Лечение направлено на контроль основного заболевания, что может улучшить показатели крови. |
| Дефицит витаминов (B12, фолиевая кислота) или микроэлементов (медь) | Сдать анализы на дефицит, принимать назначенные врачом добавки. | Врач может назначить инъекции витамина B12 или пероральные добавки. |
| Заболевания костного мозга (апластическая анемия, миелодиспластический синдром) | Срочно обратиться к гематологу для детальной диагностики и лечения. | Могут потребоваться биопсия костного мозга, переливание крови, трансплантация. |
| Недостаточное питание, истощение | Скорректировать рацион, включить белки, витамины, минералы. | Консультация диетолога может быть полезна. |
| Хронические заболевания печени или селезенки | Лечить основное заболевание под наблюдением специалиста. | Улучшение функции органов может способствовать нормализации уровня лейкоцитов. |
| Воздействие радиации или токсических веществ | Избегать дальнейшего воздействия, обратиться к врачу для детоксикации и поддерживающей терапии. | Важно выявить источник воздействия и устранить его. |
| Идиопатическая лейкопения (причина не установлена) | Регулярное наблюдение у врача, контроль общего состояния и анализов крови. | Врач может рекомендовать поддерживающую терапию или дальнейшие обследования. |
| Стресс, переутомление | Обеспечить достаточный отдых, снизить уровень стресса, нормализовать режим сна. | Здоровый образ жизни способствует укреплению иммунитета. |
Неполноценный рацион
Недостаток питательных веществ, витаминов и микроэлементов приводит к снижению выработки белых кровяных клеток. Важно, чтобы рацион включал витамины группы В (В1, В9, В12), а также железо и медь. Уровень лейкоцитов уменьшается постепенно, поэтому до достижения нижней границы нормы стоит пересмотреть свое питание.
Если разработанная диета не приносит результатов, это может указывать на наличие других причин или на то, что организм не в состоянии усваивать необходимые питательные вещества. В таком случае возможно развитие анорексии и сопутствующего истощения.

Проблемы костного мозга
Развитие опухолей в костном мозге приводит к замещению нормальной гемопоэтической ткани, которая отвечает за образование белых кровяных клеток. Снижение уровня лейкоцитов в крови является признаком нарушения функционирования костной ткани.
Заболевания костного мозга могут вызывать уменьшение выработки лейкоцитов. Лейкопения может возникать по следующим причинам:
- наследственные болезни костной системы;
- злокачественные опухоли костной ткани;
- метастазы и рост опухолевых образований.
Во время интоксикации костный мозг временно прекращает выполнять свои функции. Патологические процессы могут быть спровоцированы злоупотреблением наркотиками, воздействием радиоактивного излучения, алкоголем, пищевыми отравлениями, а также попаданием в организм таких веществ, как мышьяк, толуол, ртуть и другие тяжелые металлы. Снижение уровня лейкоцитов в крови также наблюдается после проведения химиотерапии.
Болезни внутренних органов
При наличии патогенных процессов, таких как воспаления или гнойные образования, количество белых кровяных клеток в кровотоке может значительно снижаться, так как они направляются в области инфекции. Это свидетельствует о защитной роли лейкоцитов. В такой период общее количество эритроцитов в организме может увеличиваться из-за их активного производства.
В других случаях уровень лейкоцитов может падать практически до нуля, когда они разрушаются в процессе борьбы с патогенами. За время жизни одной лейкоцита он способен уничтожить множество вирусов и бактерий.
Снижение уровня лейкоцитов может быть связано с заболеваниями внутренних органов:
- повышенной выработкой гормонов щитовидной железы;
- заболеваниями печени и селезёнки;
- нарушениями в работе желудочно-кишечного тракта;
- почечной недостаточностью.
Также отмечено, что значительное снижение количества белых кровяных клеток может происходить при приеме некоторых медикаментов. К ним относятся: анальгетики, барбитураты, цитостатики, противосудорожные средства, сульфаниламиды, антидепрессанты, левомицитин и интерферон.
https://youtube.com/watch?v=IvMhtrlimuQ
Симптомы заболевания
Лейкопения может проявляться слабо, особенно в легкой форме. Однако, когда уровень белых кровяных клеток становится критически низким, это начинает сказываться на здоровье, особенно если патологические процессы становятся хроническими. Подозрение на проблемы с иммунной системой может возникнуть, если в организм проникает инфекция, что приводит к выраженным симптомам интоксикации.
Симптомы длительной лейкопении:
- Температура тела резко повышается до 37−38 градусов без явных причин, при этом отсутствуют признаки инфекционных заболеваний (такие как покраснение горла, выделения из носа, кашель).
- Появляются головные боли, снижается аппетит.
- Наблюдаются боли в грудной клетке, повышенное потоотделение и учащенное сердцебиение.
- Лимфатические узлы увеличиваются, возникают боли в суставах.
- Чувствуется общая слабость, учащается сердцебиение.
При наличии лейкопении быстрое развитие инфекции может привести к септическому шоку. Если изменения вызваны вирусами, необходимо обратиться за консультацией к иммунологу и инфекционисту.
Снижение форменных элементов
В процессе диагностики общего анализа крови важно обращать внимание не только на общий уровень лейкоцитов, но и на их различные подтипы. В некоторых случаях общий показатель лейкоцитов может находиться в пределах нормы, однако наблюдается снижение количества базофилов, моноцитов или лимфоцитов. Это свидетельствует о снижении уровня конкретного типа клеток, даже если общий объем лейкоцитов остается нормальным.
Малое содержание нейтрофилов
Низкие уровни нейтрофилов, которые играют ключевую роль в защите организма от инфекций, могут указывать на наличие нейтропении. Снижение их количества может быть как временным, так и постоянным. При врождённой форме заболевания нейтрофилы могут снижаться на 3−6 дней каждые 3−4 недели.
Среди факторов, способствующих уменьшению количества нейтрофилов, можно выделить:
- Вирусные инфекции, сопровождающиеся высокой температурой, а также гнойные заболевания.
- Панцитопения, включая апластическую анемию, при которой происходит снижение образования всех типов клеток крови.
- Септицемия.
- Анемия, вызванная нехваткой витаминов группы В.
- Состояния, связанные с гиперспленическим синдромом и прострацией.
- Язвы желудка, холецистит и гастрит.
- Состояние шока.
У взрослых людей с низким уровнем нейтрофилов и лейкоцитов может развиться осложнение ревматоидного артрита, известное как синдром Фелти.

Низкие эозинофилы
Снижение уровня эозинофилов может свидетельствовать о наличии паразитарных инфекций или аллергических реакциях, таких как отёк Квинке, нейродермит и астма. Эозинопения фиксируется при уменьшении количества лейкоцитов — эозинофилов до 0,2 тыс./мкл и ниже.
Полное отсутствие эозинофилов называется анэозинофилией. К основным причинам снижения уровня этих лейкоцитов можно отнести:
- острые инфекционные заболевания;
- эклампсию и сепсис;
- запущенные формы туберкулёза;
- пернициозную анемию;
- восстановительный период после хирургических вмешательств или родов.
Низкий уровень лейкоцитов в сочетании с пониженными эозинофилами указывает на ослабление иммунной системы и снижение защитных функций организма.
Понижение базофилов
Базофилы играют важную роль в аллергических реакциях. Снижение уровня лейкоцитов базофилов может свидетельствовать о наличии аутоиммунных и иммунных заболеваний, а также проблем с эндокринной и нервной системами. Состояние, при котором наблюдается низкий уровень базофилов (базопения), может возникать в следующих случаях:
- болезнь Базедова;
- гипертиреоз;
- во время овуляции и беременности;
- на остром этапе пневмонии или в условиях стресса;
- при наличии гормональной опухоли или синдроме Кушинга.
После перенесённого тяжёлого инфекционного заболевания уровень базофилов может также снижаться. Низкие показатели могут быть зафиксированы при воздействии малых доз радиации.
Уменьшение лимфоцитов
Сниженный уровень лимфоцитов (лимфопения) может быть естественным явлением. У женщин во время беременности наблюдается уменьшение количества лимфоцитов на 25%. В обычных условиях низкий уровень лимфоцитов может свидетельствовать о наличии заболеваний.
Отклонения от нормальных значений могут возникать:
- при туберкулёзе лимфатических узлов и лимфогранулематозе;
- при системной красной волчанке;
- в условиях лучевой болезни и стресса;
- при почечной недостаточности.
Лимфоциты играют ключевую роль в иммунной системе. Снизить их уровень можно с помощью гормональных препаратов и иммунодепрессантов. При наличии иммунодефицита возрастает вероятность заражения ВИЧ-инфекцией.
Недостаток моноцитов
Моноциты играют ключевую роль в борьбе с инфекциями, осуществляя процесс фагоцитоза. Снижение уровня этих клеток в крови называется моноцитопенией. Дефицит моноцитов может наблюдаться в следующих случаях:
- При тяжелых формах сепсиса.
- В результате инфекционных заболеваний и интоксикаций.
- При анемии, вызванной нехваткой витамина В12.
- Лейкопеническая форма лейкоза может быть основной причиной снижения уровня моноцитов, так как при этом заболевании нарушается процесс созревания лейкоцитов.
Если общий уровень лейкоцитов снижен, а количество моноцитов повышено, это может свидетельствовать о том, что организм успешно справился с инфекцией. Однако у взрослых такое состояние иногда указывает на серьезные заболевания, такие как тяжелая форма туберкулеза или наличие опухолей.

Проведение диагностики
Перед началом лечения проводится анализ различных групп белых кровяных клеток. Некоторые тесты могут быть повторены несколько раз, чтобы отслеживать динамику изменений в показателях — как в сторону ухудшения, так и в сторону нормализации. Только врач может точно определить причины отклонений в уровне лейкоцитов.
После выявления причин лейкопении назначается соответствующая терапия. В случае повреждения костного мозга используются медикаменты, такие как Ленограстим, Саграмостин и Филграстим. В сложных ситуациях, связанных с злокачественными опухолями, может потребоваться переливание крови, химиотерапия или пересадка костного мозга.
Методы лечения
При нарушениях работы эндокринной системы и внутренних органов лечение назначается в зависимости от конкретного заболевания. В случае выявления инфекции применяются антигистаминные средства, антибиотики и противовирусные препараты.
Если показатели крови остаются в пределах нормы, а количество белых клеток не превышает допустимый минимум, то корректировка питания становится основным методом. Однако при значительном снижении лейкоцитов требуется медикаментозная терапия под наблюдением специалиста.
В рамках лечения назначаются витаминно-минеральные комплексы, которые помогают восполнить нехватку витаминов группы В. К таким препаратам относятся: Пентоксил, Лейкоген, Батилол и Метилурацил. Эти средства способствуют увеличению уровня белых кровяных клеток, воздействуя на костный мозг.
Сократить время восстановления лейкоцитов можно с помощью правильного питания. В рацион следует включить:
- Цитрусовые, фрукты и ягоды.
- Низкокалорийные молочные продукты с низким содержанием жира.
- Свежие овощи и цельнозерновые крупы.
- Рыбу и нежирное мясо. Белок должен составлять основную часть рациона.
- Отвар ячменя. Для его приготовления один стакан крупы варят в 1,5−2 литрах воды до уменьшения объема жидкости вдвое. Рекомендуется принимать по стакану дважды в день.
Во время лечебной диеты следует ограничить потребление копченостей и жареных блюд, исключить полуфабрикаты и жирные продукты. Основу рациона составляют горячие блюда, приготовленные на овощном, рыбном или мясном бульоне, а также натуральные соки, компоты, паровые котлеты и тефтели. Питание должно быть дробным, 5−6 раз в день. Суточная калорийность для женщин составляет около 3000 калорий, для мужчин — 3300−3500 калорий.
Когда уровень лейкоцитов в крови немного снижен, но не опускается ниже критической отметки, важно придерживаться профилактических мер. Это включает соблюдение диеты, полноценный отдых и практики для эмоциональной разгрузки. Режим жизни человека с лейкопенией практически не отличается от жизни здорового человека, однако следует уделять больше внимания защите организма от вирусов и бактерий.
Профилактика лейкопении
Сбалансированное питание играет ключевую роль в поддержании нормального уровня лейкоцитов. В рационе должны присутствовать:
- Продукты, богатые витаминами и минералами, особенно витамином C (цитрусовые, ягоды, брокколи) и витамином B12 (мясо, рыба, молочные продукты).
- Продукты, содержащие фолиевую кислоту (зеленые листовые овощи, бобовые, орехи), которая способствует образованию новых клеток крови.
- Продукты, богатые цинком (мясо, морепродукты, семена), который необходим для нормального функционирования иммунной системы.
2. Избегание токсинов
Снижение воздействия токсичных веществ, таких как алкоголь, табак и химические вещества, может помочь предотвратить лейкопению. Ограничение или исключение этих веществ из жизни способствует улучшению общего состояния организма и поддержанию нормального уровня лейкоцитов.
3. Укрепление иммунной системы
Регулярные физические нагрузки, такие как прогулки, занятия спортом или йогой, способствуют укреплению иммунной системы. Умеренные физические нагрузки помогают улучшить кровообращение и способствуют более эффективному функционированию всех систем организма.
4. Регулярные медицинские обследования
Важно проходить регулярные медицинские обследования и анализы крови, чтобы контролировать уровень лейкоцитов и выявлять возможные проблемы на ранних стадиях. Это особенно актуально для людей с хроническими заболеваниями или теми, кто принимает лекарства, влияющие на уровень лейкоцитов.
5. Управление стрессом
Стресс может негативно влиять на иммунную систему и уровень лейкоцитов. Практики релаксации, такие как медитация, глубокое дыхание и занятия хобби, могут помочь снизить уровень стресса и улучшить общее самочувствие.
6. Избегание инфекций
Людям с пониженным уровнем лейкоцитов следует избегать мест с большим скоплением людей и соблюдать правила личной гигиены, чтобы снизить риск инфекций. Вакцинация против инфекционных заболеваний также может быть важной мерой профилактики.
Следуя этим рекомендациям, можно значительно снизить риск развития лейкопении и поддерживать здоровье на высоком уровне. Важно помнить, что при наличии симптомов или подозрений на лейкопению необходимо обратиться к врачу для получения квалифицированной медицинской помощи.
Рекомендации по образу жизни
Когда уровень лейкоцитов в крови понижен, важно обратить внимание на образ жизни и внести в него изменения, которые помогут улучшить общее состояние здоровья и поддержать иммунную систему. Вот несколько рекомендаций, которые могут оказаться полезными:
1. Правильное питание
Сбалансированное питание играет ключевую роль в поддержании нормального уровня лейкоцитов. Включите в свой рацион:
- Фрукты и овощи: Они богаты витаминами, минералами и антиоксидантами, которые способствуют укреплению иммунной системы. Особенно полезны цитрусовые, ягоды, брокколи и шпинат.
- Продукты, богатые белком: Белок необходим для производства лейкоцитов. Включите в рацион мясо, рыбу, яйца, бобовые и молочные продукты.
- Здоровые жиры: Омега-3 жирные кислоты, содержащиеся в рыбе, орехах и семенах, могут помочь уменьшить воспаление и поддержать иммунный ответ.
- Цельнозерновые продукты: Они обеспечивают организм необходимыми углеводами и клетчаткой, что способствует нормализации обмена веществ.
2. Регулярная физическая активность
Умеренные физические нагрузки способствуют улучшению кровообращения и укреплению иммунной системы. Рекомендуется:
- Заниматься аэробными упражнениями, такими как ходьба, бег, плавание или велосипед.
- Включать в тренировки силовые упражнения для поддержания мышечной массы.
- Практиковать йогу или пилатес для улучшения гибкости и снижения стресса.
3. Управление стрессом
Хронический стресс может негативно влиять на уровень лейкоцитов. Для его снижения можно:
- Практиковать медитацию и дыхательные упражнения.
- Заниматься хобби или творчеством, что помогает отвлечься от повседневных забот.
- Общаться с близкими и друзьями, что способствует эмоциональной поддержке.
4. Достаточный сон
Качественный сон необходим для восстановления организма и поддержания иммунной функции. Рекомендуется:
- Соблюдать режим сна, ложиться и вставать в одно и то же время.
- Создавать комфортные условия для сна: затемненное и тихое помещение, удобная постель.
- Избегать употребления кофеина и тяжелой пищи перед сном.
5. Избегание вредных привычек
Курение и чрезмерное употребление алкоголя могут негативно сказаться на уровне лейкоцитов и общем состоянии здоровья. Рекомендуется:
- Отказаться от курения и избегать пассивного курения.
- Ограничить потребление алкоголя, придерживаясь рекомендаций по умеренности.
Следуя этим рекомендациям, можно значительно улучшить общее состояние здоровья и способствовать нормализации уровня лейкоцитов в крови. Однако важно помнить, что при низком уровне лейкоцитов необходимо обратиться к врачу для выявления причин и назначения соответствующего лечения.
Психологическая поддержка и стресс-менеджмент
Когда уровень лейкоцитов в крови понижен, это может вызывать не только физические, но и психологические проблемы. Люди, столкнувшиеся с этой ситуацией, могут испытывать тревогу, страх и неопределенность относительно своего здоровья. Поэтому важно уделить внимание не только физическому состоянию, но и психологическому комфорту.
Первым шагом к улучшению психологического состояния является получение информации о своем диагнозе. Понимание причин пониженного уровня лейкоцитов и возможных последствий может помочь снизить уровень тревожности. Обсуждение своего состояния с врачом и получение четких рекомендаций по дальнейшим действиям может значительно улучшить эмоциональное состояние пациента.
Также важно создать поддерживающую среду. Общение с близкими, друзьями и другими людьми, которые могут понять и поддержать, играет ключевую роль в процессе восстановления. Поддержка со стороны окружающих может помочь справиться с негативными эмоциями и повысить уровень уверенности в себе.
Стресс-менеджмент является важным аспектом в поддержании психологического здоровья. Различные техники релаксации, такие как медитация, йога или дыхательные упражнения, могут помочь снизить уровень стресса и улучшить общее самочувствие. Регулярные физические упражнения также способствуют выработке эндорфинов, которые улучшают настроение и помогают справляться с тревожностью.
Важно также обратить внимание на режим сна и питания. Недостаток сна может усугубить стресс и негативно сказаться на общем состоянии здоровья. Установление регулярного режима сна и употребление сбалансированной пищи, богатой витаминами и минералами, поможет укрепить иммунную систему и улучшить общее самочувствие.
Если тревога и стресс становятся невыносимыми, стоит обратиться за профессиональной помощью. Психотерапия может стать эффективным инструментом для работы с эмоциями и стрессом. Психолог или психотерапевт поможет разобраться в чувствах, научит справляться с негативными мыслями и предоставит стратегии для улучшения качества жизни.
В заключение, важно помнить, что пониженный уровень лейкоцитов в крови — это не только физическая проблема, но и психологическая. Забота о своем психоэмоциональном состоянии, использование техник стресс-менеджмента и обращение за поддержкой помогут справиться с трудностями и улучшить качество жизни.